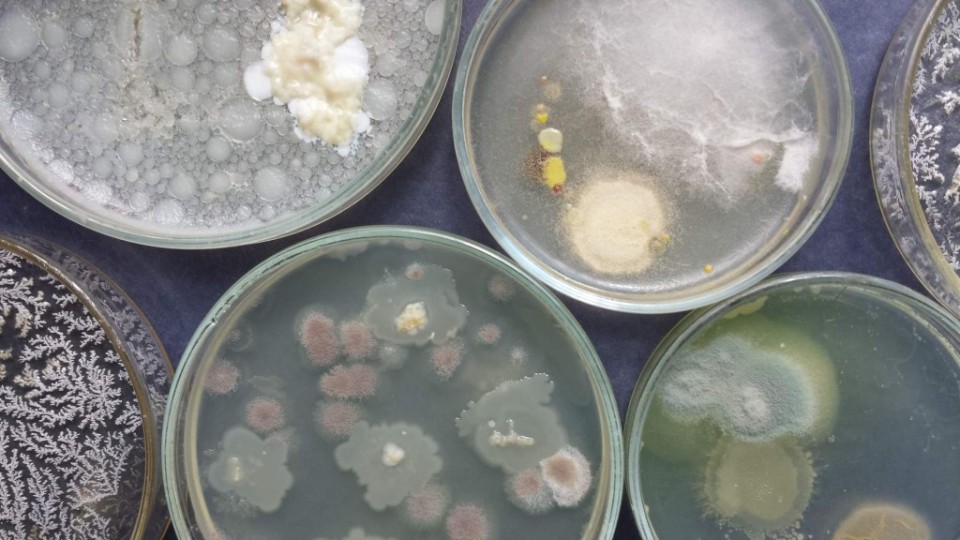
201404272128_agar56

Výsledky mikrobiologických laboratorních cvičení žáků 4.B, kdy se naučili kultivovat vzorky odebrané ve vile, běžné plísně a lipofilní bakterie v půdě, připravovat agarová média a očkovat zředěné kolonie.
FOTKY ZDE
SOŠ pro ochranu a obnovu životního prostředí - Schola Humanitas, Litvínov, Ukrajinská 379
/
(00420) 476 111 226
/
Kontaktujte nás
Kategorie: Laborky
07
Bře2014
Žáci 4. B dnes absolvovali další laboratorní cvičení z mikrobiologie. Po zvládnutí přípravy agarového média si vyzkoušeli očkování a sběr vzorků pro pěstování kultur. Vhodné zdroje pro kultivaci našli v budově vily.
FOTKY
VIDEO
07/03/2014Schola Humanitas
27
Led2014
Pár fotek od druháků, jak vyráběli v chemii acetylen.
FOTKY ZDE.
27/01/2014Schola Humanitas
07
Pro2013
Třeťáci v biologii pitvali srdce. Fotky vidělo už 600 lidí a teď se ně můžete podívat i vy.
ZDE FOTKY
ZDE VIDEO
07/12/2013Schola Humanitas
07
Pro2013
Několik fotek druháků z hodiny chemie, kde tvořili vzorce chemických rovnic.
FOTKY ZDE
07/12/2013Schola Humanitas
26
Lis2013
Laboratorní praktika třídy 2.B, na kterém vyráběli ethylen.
FOTKY ZDE
VIDEO ZDE
26/11/2013Schola Humanitas
08
Čer2013
Fotky prváků, jak vyrábí v laborkách chemie vodík. Za fotky děkuji Pavlíně V.
FOTKY ZDE.
08/06/2013Schola Humanitas
08
Čer2013
Fotky druháků jak v chemie izolovali destilací ethanol.
FOTKY ZDE.
VIDEO ZDE.
08/06/2013Schola Humanitas
01
Dub2013
V chemické laboratoři ve středu druháci prováděli neutralizační titraci (stanovení obsahu kyseliny octové ve vzorku octa). Tak se na to můžete podívat.
FOTKY jsou ZDE.
VIDEO je ZDE.
01/04/2013Schola Humanitas
14
Úno2013
Druháci pozorovali v laborce biologie stavbu těla krevety.
Zde je pár FOTEK.
Zde krátké VIDEO.
14/02/2013Schola Humanitas